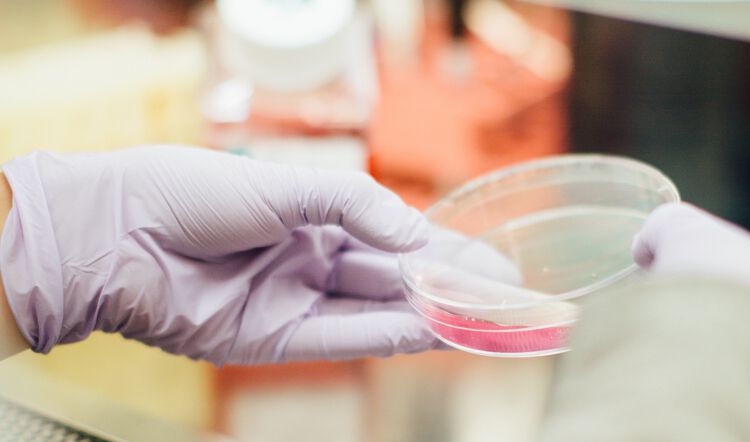

It's not uncommon for there to be more than one FSA in a single household. Since an FSA lets you apply tax-free dollars towards eligible medical expenses, it makes sense financially for everyone in the family to take advantage of the benefit if they can.
But understanding how to manage two accounts under the same roof can be confusing when there are so many policies in place that you need to follow. So what's the proper use of an FSA when you have more than one in your household?

Be wary of "double dipping"
The most important thing to remember when you have more than one FSA in your household is that each expense can only be reimbursed once. That's because, according to the IRS, any expense that's already been reimbursed is no longer eligible for any further reimbursement. Being reimbursed for a single expense more than once is commonly referred to as "double dipping."
When there's more than one FSA in the household, double dipping often happens when one person submits a claim on a medical expense, and then another person submits a claim on the same expense with their own FSA.
Let's say, the child of two parents who each have their own FSA is getting braces, only one of the parents can submit the expense for reimbursement. The other parent can't claim any portion of the covered expense on their own FSA.
Double dipping also applies to items purchased with an FSA debit card. If one person pays for an expense with their FSA card, no one else can submit a claim for it on their FSA.
FSA administrators require you to acknowledge the no double dipping rule at the beginning of your plan enrollment. Whenever you submit a claim, you'll also be confirming that the expense wasn't already reimbursed and that you won't submit it for reimbursement elsewhere.
Yes, there are some penalties
Some people think that double dipping is easier to get away with when there's more than one account in the household. Just remember that regardless of which FSA you're submitting the claim to, you still need to provide detailed information about the service or items purchased. If you continuously try to get away with double dipping, your administrator will catch it.
Not only is double dipping unethical, but it can result in severe consequences. If your administrator discovers that an expense was reimbursed more than once, you'll be required to pay the amount back. And If they find that your plan hasn't been compliant with regulations, your employer may face harsh penalties.
Honesty is still the best policy
In a household with two FSAs, it's easy for one person to submit a claim without the other person being aware of it, which can lead to the second person submitting a claim for the same exact thing.
The best way to avoid this is to keep track of expenses and claims in an organized way. Keep receipts for everything that's purchased with an FSA card in one place, and always look through them before filing a claim to make sure it wasn't already reimbursed. (One of our authors had some good tips for keeping HSA records in order, and we recommend trying the same for your FSA.)
Like our teachers always told us, be honest. Your FSA is no exception. Of course, not all instances of double dipping are intentional. And yes, honest mistakes do happen, but by taking the necessary precautions, they can be avoided.
-
Thank you for visiting the FSA Store Learning Center! Don’t forget to follow us for more helpful tips on Facebook, Instagram and Twitter.